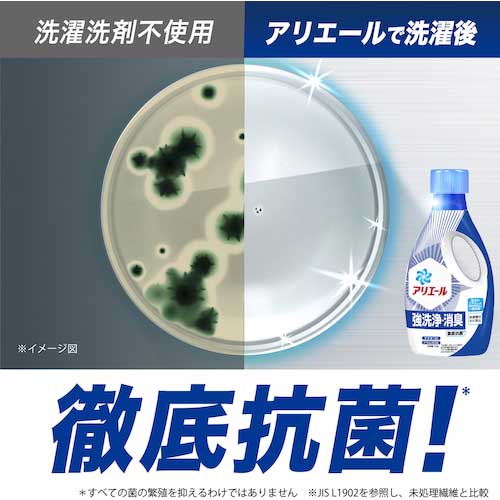

新入荷再入荷
高評価アイテム Amazon アリエール | 450g 詰め替え 超抗菌ジェル アリエール | 洗濯洗剤
 タイムセール
タイムセール
終了まで
00
00
00
999円以上お買上げで送料無料(※)
999円以上お買上げで代引き手数料無料
999円以上お買上げで代引き手数料無料
通販と店舗では販売価格や税表示が異なる場合がございます。また店頭ではすでに品切れの場合もございます。予めご了承ください。
商品詳細情報
| 管理番号 | 中古 :4871361512 | 発売日 | 2025-06-13 17:58 | 定価 | 7000円 | 型番 | 4871361512 | ||
|---|---|---|---|---|---|---|---|---|---|
| カテゴリ | |||||||||
高評価アイテム Amazon アリエール | 450g 詰め替え 超抗菌ジェル アリエール | 洗濯洗剤
 Amazon | アリエール 超抗菌ジェル 詰め替え 450g | アリエール,
Amazon | アリエール 超抗菌ジェル 詰め替え 450g | アリエール, 楽天市場】アリエール ジェルの通販,
楽天市場】アリエール ジェルの通販,![Amazon | [ケース品] [大容量] アリエール ジェル 洗濯洗剤 液体 Amazon | [ケース品] [大容量] アリエール ジェル 洗濯洗剤 液体](https://m.media-amazon.com/images/I/71Qz4QBV2VL._AC_UF350,350_QL80_.jpg) Amazon | [ケース品] [大容量] アリエール ジェル 洗濯洗剤 液体,
Amazon | [ケース品] [大容量] アリエール ジェル 洗濯洗剤 液体, 廃番】P&G アリエール 超抗菌ジェル 詰め替え 超特大 900gアリエール超抗菌ジェル/オタフクソース詰め替え4袋♛アリエール超抗菌ジェル1.68kg×5袋 増量タイプ1.59kg×3袋パッケージにしわなどあります。多目的洗剤 ココナツ洗剤 大容量18リットル缶。♛オタフクソース詰め替え4袋420g4袋賞味期限2026.3パッケージにしわなどあります。マザータッチ 洗濯用 詰替用 5L グリーン & オレンジ 各1本。簡易包装での配送です。トップハレタセット。そのまま箱にお詰めします。【ケース販売】アタックZERO 洗濯洗剤 液体 詰め替え2000g×4個。
廃番】P&G アリエール 超抗菌ジェル 詰め替え 超特大 900gアリエール超抗菌ジェル/オタフクソース詰め替え4袋♛アリエール超抗菌ジェル1.68kg×5袋 増量タイプ1.59kg×3袋パッケージにしわなどあります。多目的洗剤 ココナツ洗剤 大容量18リットル缶。♛オタフクソース詰め替え4袋420g4袋賞味期限2026.3パッケージにしわなどあります。マザータッチ 洗濯用 詰替用 5L グリーン & オレンジ 各1本。簡易包装での配送です。トップハレタセット。そのまま箱にお詰めします。【ケース販売】アタックZERO 洗濯洗剤 液体 詰め替え2000g×4個。



























